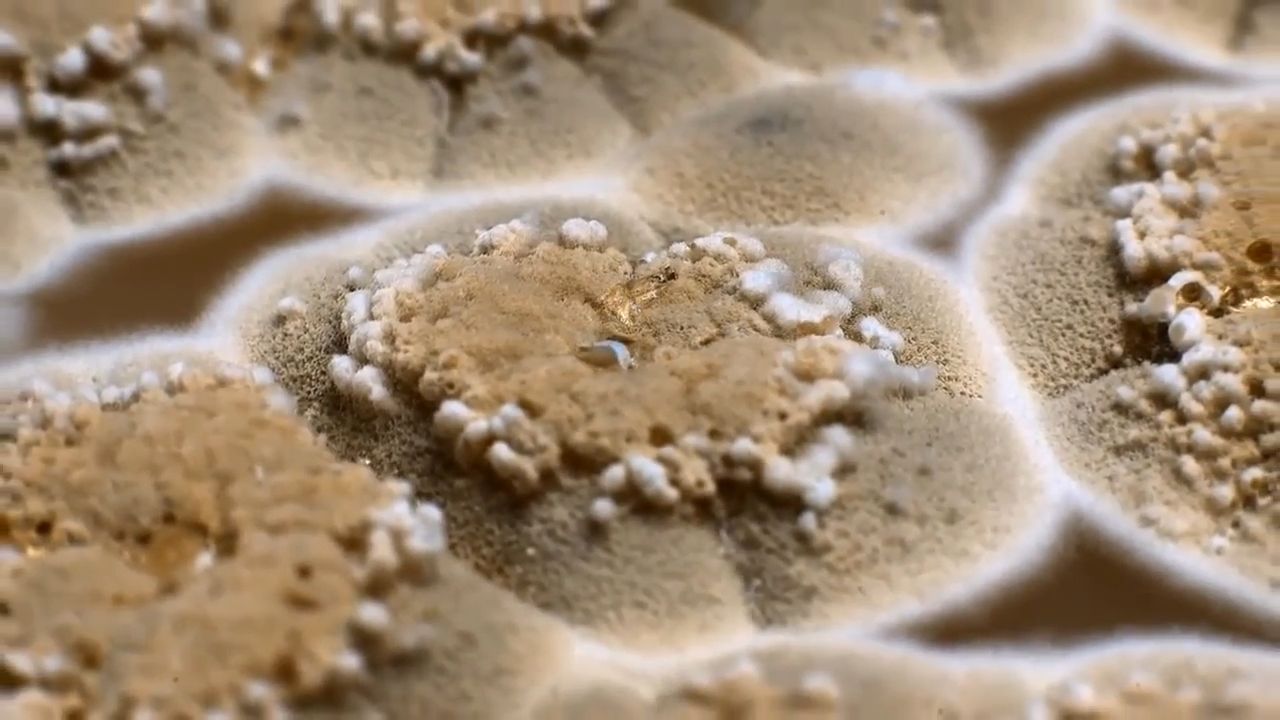
Göbələklər

- Turkish / Türkçe
- Azerbaijani / Azərbaycanca
- Russian / Русский
- English
- Portuguese / Português
- Dutch / Nederlands
- Italian / Italiano
- Spanish / Español
- German / Deutsch
- Persian / فارسی
- Polish / Polski
- French / Français
- Albanian / Shqip
- Arabic / العربية
- Bulgarian / Български
- Indonesian / Bahasa Indonesia
- Bosnian / Bosanski
- Hungarian / Magyar
- Thai / ภาษาไทย
- Swedish / Svenska
- Kurdí